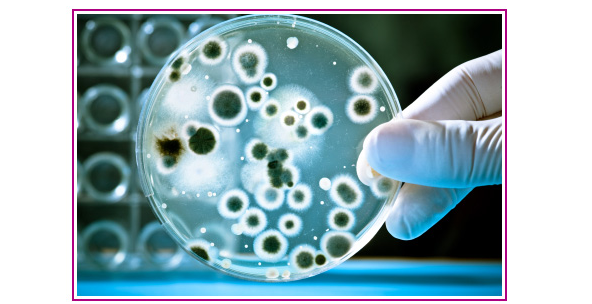

Análises de Águas
Analises de Soluções anti congelantes ( glicol )lises de Carvão Ativado
Análises de Resinas Iónicas
Analises á Legionella
Bactéria Legionella
Assistências Técnicas/ Inspeção, Regulação e Reparação de Equipamentos de Tratamento de Águas.

Limpeza, Desincrustação e Inibição de Caldeiras, Canalizações, Depósitos, Maquinas e Equipamentos de Tratº de Águas
Esterilização Química e/ou por Ultra-violetas de Circuitos de Aquecimento e Refrigeração de Ar Condicionado.

Extração e reposição de Resinas de permuta iónica em Descalcificadores e Desmineralizadores .
Fornecimento, extração e/ ou reposição de crivos / crepines de Filtros, Descalcificadores, Desmineralizadores, Desgasificadores etc.
Extração e Reposição das cargas filtrantes de areia, sílex, antracite, carvão ativado e resinas iónicas, etc, em equipamentos de tratamento de águas.
Glicolagem de Circuitos de Águas de Refrigeração, incluindo a regulação da mistura água / anti-congelante.

Limpeza, Desinfecção, Inibição e Tratamento de manutenção de tubagens, permutadores, condensadores, reatores, etc.
Limpeza Química de Geradores de Vapor e Caldeiras de Aquecimento incluindo regulação e dosagem dos produtos de manutenção.
Limpeza, Desinfecção e Esterilização de Colunas Iónicas, Filtros e Tanques Industriais de grandes dimensãoes, incluindo o transporte dos resíduos extraídos para tratamento em ETAR.